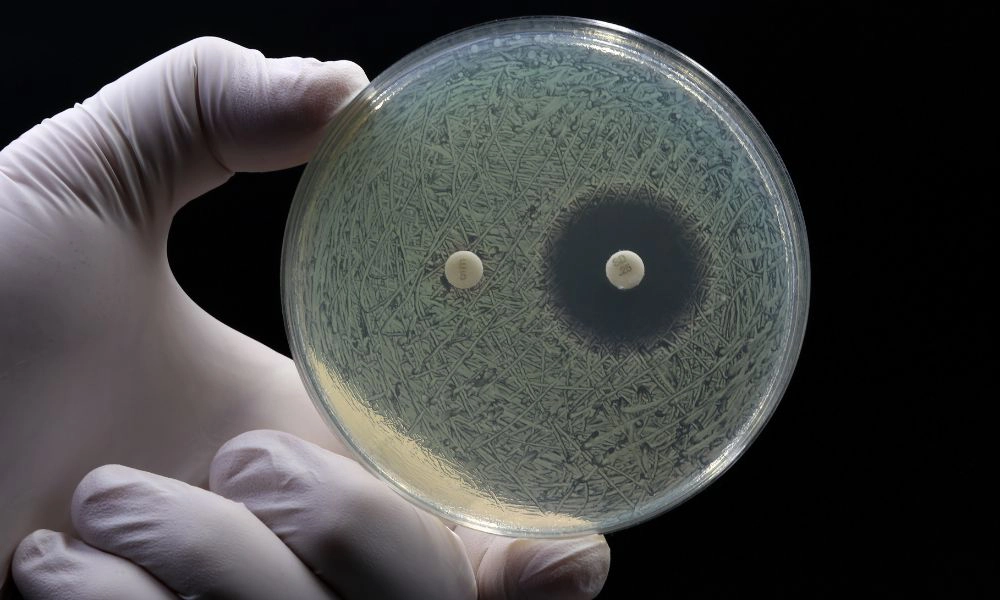

Q-POC STI Plus AMR Assay: In development
Designed for precision and efficiency at the point-of-care, Q-POC STI Plus AMR Assay is fighting against antimicrobial resistance.
Why It Matters
The Growing STI Crisis
- Globally, more than 1 million sexually transmitted infections (STIs) are acquired daily (WHO), with cases rising worldwide.
- Between 2021-2022, Neisseria gonorrhoeae cases rose by 48% across Europe (ECDC), while the U.S. reported 2.5 million new cases of chlamydia, gonorrhoea, and syphilis (CDC).
- Many STIs are asymptomatic or present with non-specific symptoms, leading to missed diagnoses and untreated infections.
- Delays in traditional lab-based testing contribute to incomplete follow-up care and further transmission.

Why Choose Q-POC STI Plus AMR Assay?

Rapid, Multiplex Testing
Detects Chlamydia trachomatis, Neisseria gonorrhoeae, Trichomonas vaginalis, and Mycoplasma genitalium in a single test, reducing the need for multiple screenings.

Rapid Point-of-Care Results
Enables immediate clinical decision-making, eliminating the delays associated with lab-based diagnostics.

AMR Detection for Targeted Treatment
Identifies resistance mutations in N. gonorrhoeae and M. genitalium to guide appropriate antibiotic use and combat antimicrobial resistance.

High Sensitivity & Specificity
Provides accurate results to ensure correct diagnoses and minimise misdiagnosis.

Compact & Easy-to-Use System
Designed for use in resource-limited settings, clinics, and urgent care centres with minimal training required.
Designed for Diverse Diagnostic Needs
Transforming STI Testing in Clinics & Point-of-Care Settings
- Ideal for sexual health clinics, urgent care, and resource-limited settings where immediate STI detection is critical.
- Reduces unnecessary antibiotic use by providing resistance mutation insights, aiding antimicrobial stewardship.
- Supports efficient clinic workflows by streamlining patient pathways and reducing follow-up visits.
- Identifies common co-infections, reducing risks of empirical therapy, treatment failure and continued infection.
- Cost-effective solution. A 4-pathogen POC strategy was found to be the most cost-effective approach (Huntingdon et al. 2018), reducing unnecessary treatments and clinic visits.

Fighting Antimicrobial Resistance (AMR)
- N. gonorrhoeae and M. genitalium are developing resistance to key antibiotics, making rapid detection critical for appropriate treatment.
- The WHO has classified N. gonorrhoeae as a high-priority antibiotic-resistant pathogen, and the CDC lists M. genitalium on its Antibiotic Resistance Threats Watch List.
- Q-POC STI Plus AMR provides essential resistance mutation detection to support responsible antibiotic prescribing and prevent further AMR development.
Partner With Us to Drive Innovation
Integrate Q-POC STI Plus AMR into your diagnostic solutions with our partnership program. Whether you’re a healthcare provider, research organisation, or distributor, we’re here to collaborate on improving point-of-care diagnostics.Explore Related Products

Q-POC Platform
Rapid molecular testing across multiple infectious diseases.

Capture XT
A novel microfluidic lab-on-a-chip sample clean up and cell concentration technology
Find the Right Solution for Your Needs
Speak to our experts to determine how Q-POC STI Plus AMR can support your diagnostic needs.Q-POC STI Plus AMR Assay FAQs
What infections does the Q-POC STI Plus AMR Assay detect?
The assay detects four key STI pathogens: Chlamydia trachomatis, Neisseria gonorrhoeae, Trichomonas vaginalis, and Mycoplasma genitalium.
How quickly does the test provide results?
How does the AMR detection work?
The test identifies resistance mutations in N. gonorrhoeae and M. genitalium, helping clinicians make informed treatment decisions.
Is this assay suitable for low-resource settings?
For more information, contact the QuantuMDx team today.